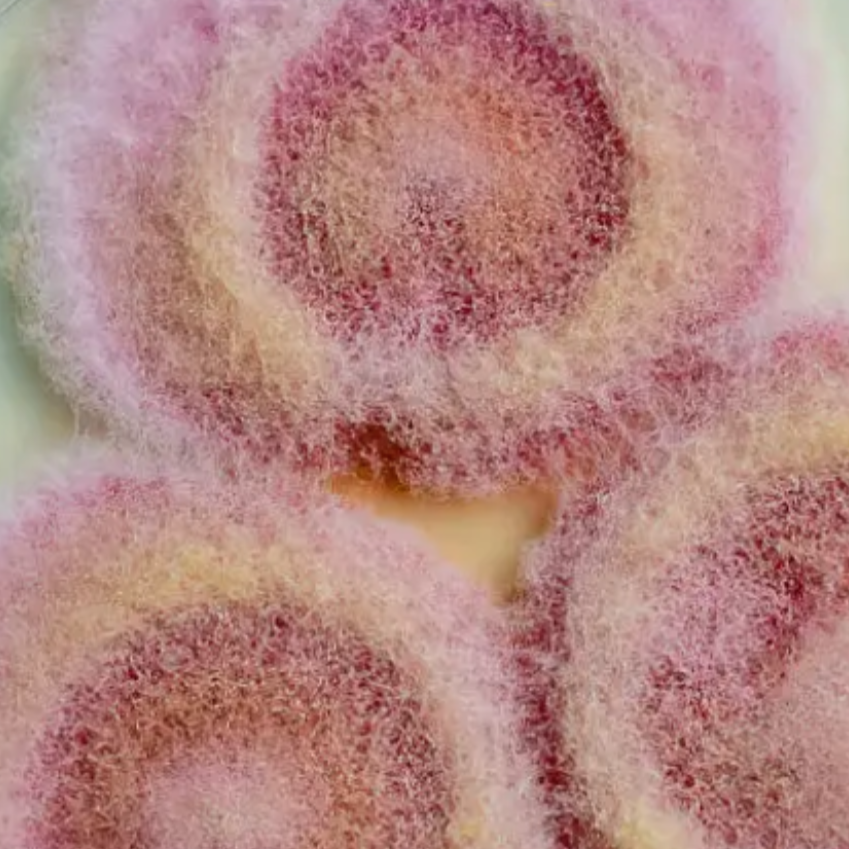
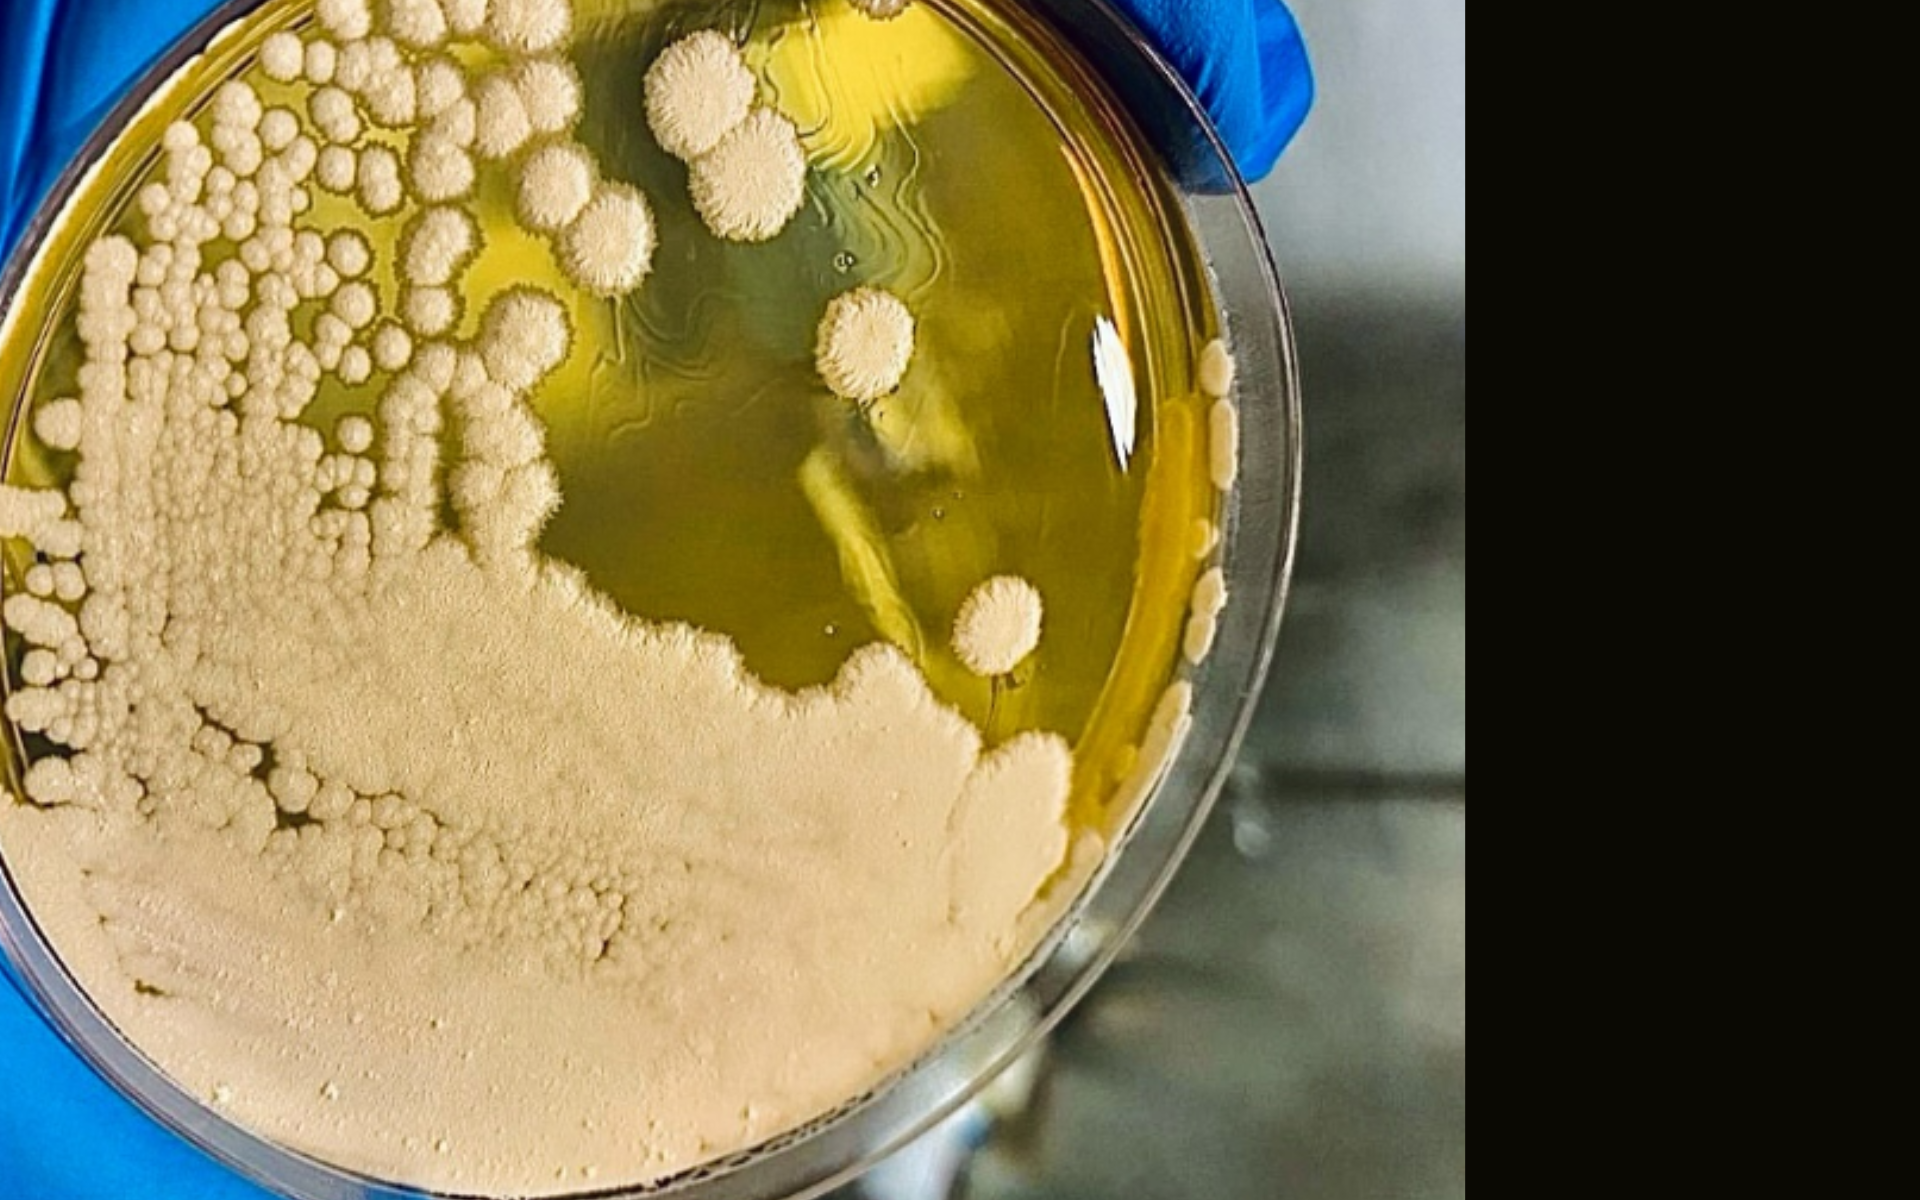
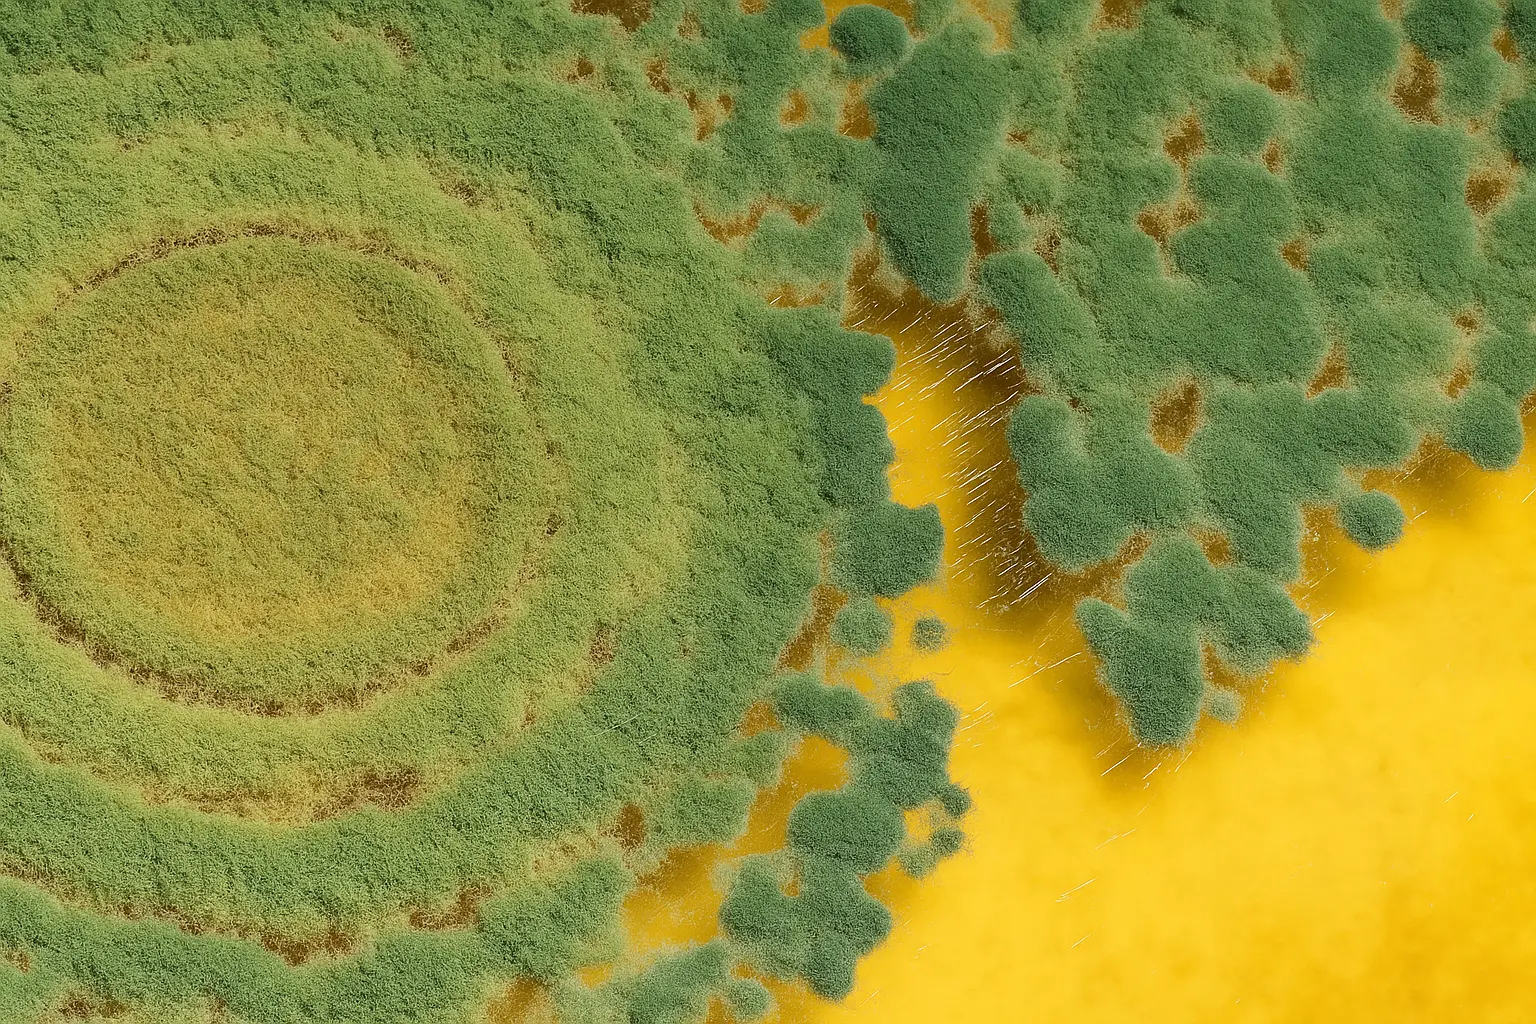
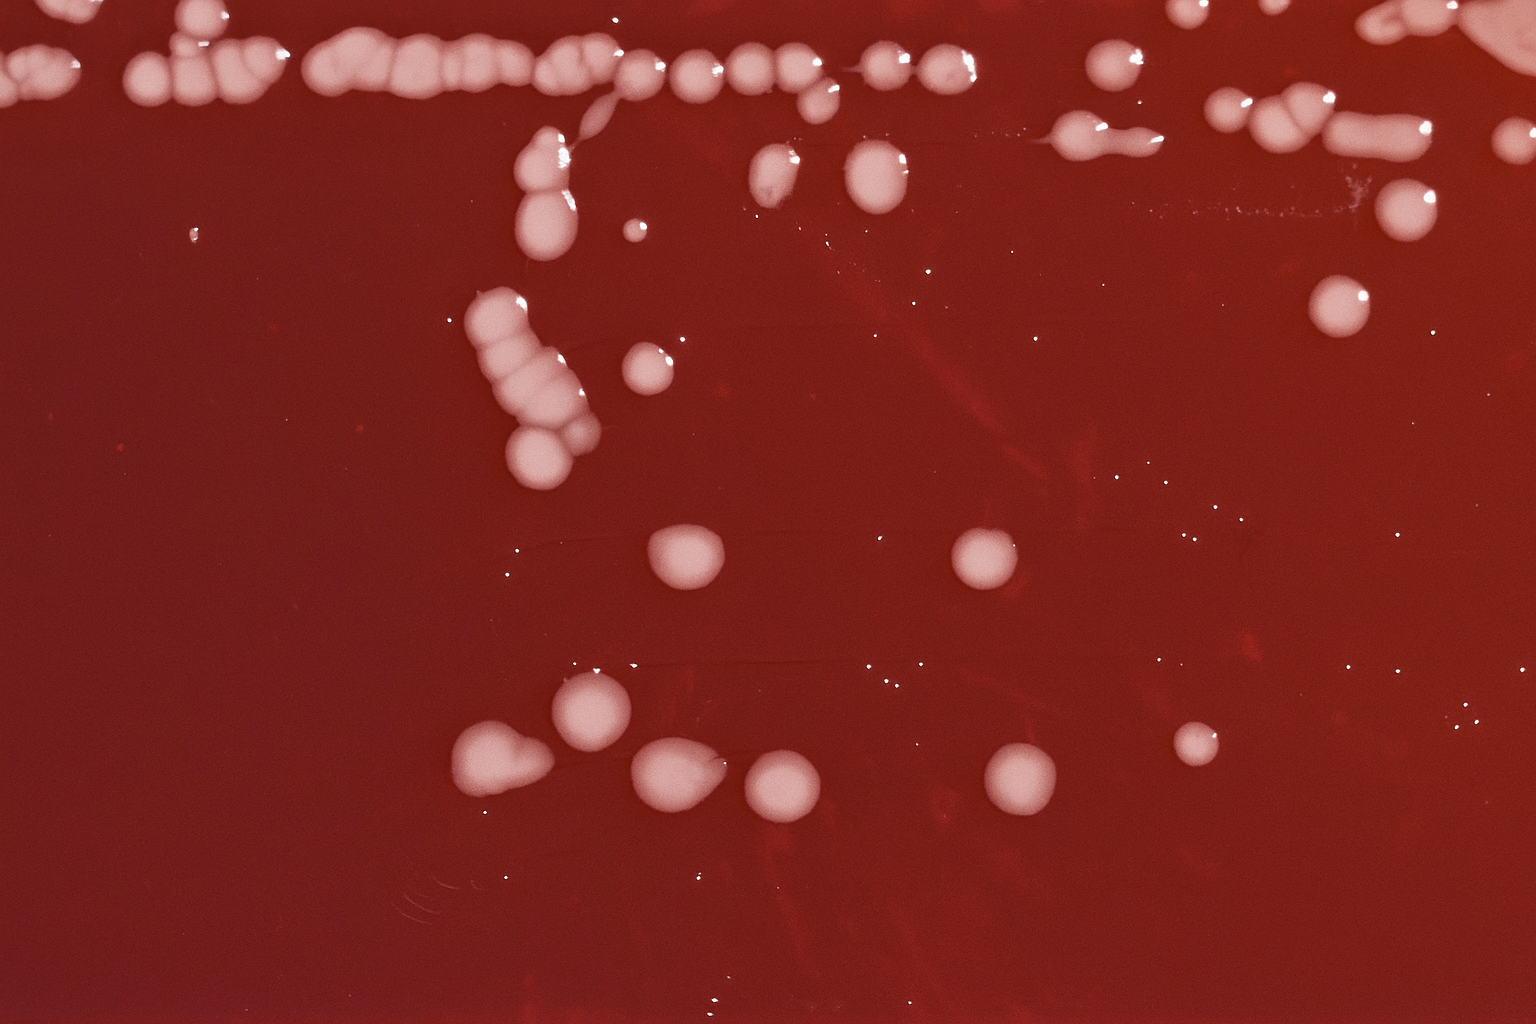

welcome
We are the Laboratory of Functional Genomics for Bioprospecting,
part of the Institute for Obesity Research at Tec Monterrey
Our mission is bold:
Decode the genomes of microorganisms and transform them into biomedical solutions against obesity and metabolic disease.
From probiotic fungi to anti-obesogenic peptides, we explore the invisible world of microbiomes to design the next generation of therapeutics, nutraceuticals, and microbial technologies.
Because understanding microbes means reshaping how we fight one of the greatest health challenges of our time.
What Makes Us Different
Collaborators
Supporting good science is at the heart of what we do.









Research lines
Fighting obesity with the power of microbiomes
At the Laboratory of Functional Genomics for Bioprospecting, we study the genomes and metabolites of microorganisms—with a special focus on fungi—to discover new strategies that tackle obesity and related metabolic disorders.
READ MORE
Synthetic biology of filamentous fungi
READ MORE
Microbiome of the Mexican population and discovery of new probiotic fungi

READ MORE
Genomic mining for biomedical molecules
in the press
Genomics is reshaping human nutrition in LATAM
Interviewed by Dr. Gustavo Gutiérrez Espeleta (University of Costa Rica), Dr. José Manuel Villalobos (Tec de Monterrey) explained how genomics is tackling major health and food challenges in Latin America: from the rise of obesity driven by ultra-processed diets, to the loss of microbiota diversity in urban populations, and the genomic sequencing of crops like agave and papaya to protect regional food security.
Around the lab
Open positions
If you can’t find what you’re looking for here, please contact us.
To conduct your bachelor’s thesis in Villalobos Lab:
(1) Prepare your CV with academic achievements.
(2) Email jose.villalobos@tec.mx to schedule an interview.
Thesis projects are based on ongoing research in mycology and biotechnology.
For general undergraduate admission info, visit Tec Undergraduate Admissions
First, get in touch with an educational advisor through the Tec website.
If you are specifically interested in joining Villalobos lab, email jose.villalobos@tec.mx with:
Choose one of lines: (1) Food and nutrigenomics biotechnology, (2) Bioprocess engineering, (3) Pharmaceutical and medical biotechnology.
Exam: PAEP ≥ 585 / 800
English: TOEFL ≥ 550 (80 IBT)
Two letters of recommendation
Curriculum vitae
Scholarship: CONAHCYT (full)
First, get in touch with an educational advisor through the Tec website.
If you are specifically interested in joining Villalobos lab, email jose.villalobos@tec.mx with:
Entrance Exam: PAEP ≥ 585 / 800
English: TOEFL ≥ 550 (80 IBT)
Two letters of recommendation
Curriculum vitae
Scholarship: CONAHCYT (full)
At the moment, we do not have specific opportunities open.

Contact with Dr. Villalobos
Looking to launch an OMICs collaboration or explore research–industry partnerships?
We thrive on collaboration and are committed to turning science into impact. No project is too early or too ambitious.
Email to jose.villalobos@tec.mx